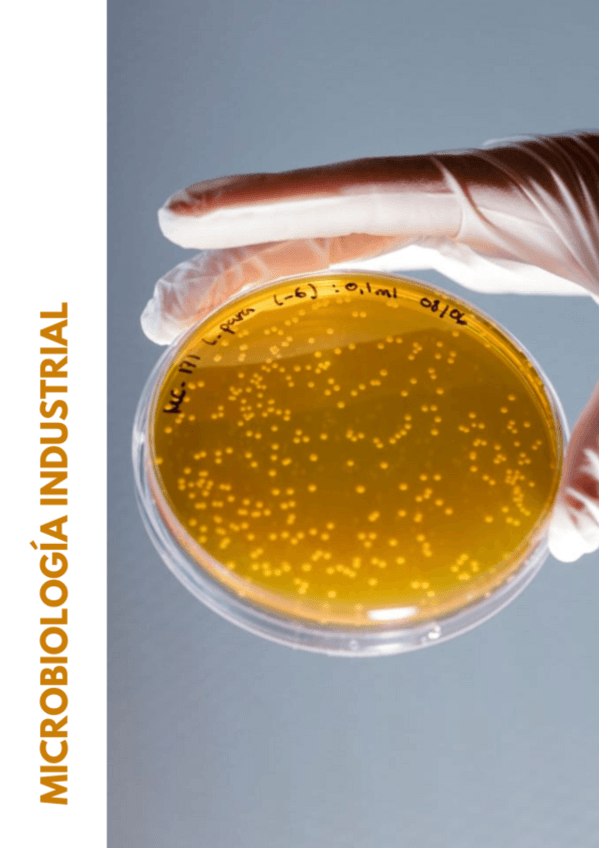

Microbiología Industrial
He publicado nuevos examenes de 3º Microbiología Industrial: Recopilacion-preguntas-desarrollo-y-test-2o-parcial-MI.pdf
apuntes
-
Esquemas temario parcial 2
He publicado nuevos apuntes de 3º Microbiología Industrial: Esquemas temario parcial 2
He publicado nuevos apuntes de 3º Microbiología Industrial: POSIBLES-PREGUNTAS-TEMA-14.pdf
He publicado nuevos apuntes de 3º Microbiología Industrial: POSIBLES-PREGUNTAS-TEMA-13.pdf
He publicado nuevos apuntes de 3º Microbiología Industrial: POSIBLES-PREGUNTAS-TEMA-12.pdf
He publicado nuevos apuntes de 3º Microbiología Industrial: POSIBLES-PREGUNTAS-TEMA-11.pdf
He publicado nuevos apuntes de 3º Microbiología Industrial: POSIBLES-PREGUNTAS-TEMA-10.pdf
examenes
-
Test segundo parcial
He publicado nuevos examenes de 3º Microbiología Industrial: Test segundo parcial
He publicado nuevos examenes de 3º Microbiología Industrial: POSIBLES-PREGUNTAS-TEMA-9.pdf
He publicado nuevos apuntes de 3º Microbiología Industrial: apuntestema12.docx
He publicado nuevos apuntes de 3º Microbiología Industrial: apuntestema13.docx
He publicado nuevos apuntes de 3º Microbiología Industrial: apuntestema11.docx
He publicado nuevos apuntes de 3º Microbiología Industrial: apuntestema10.docx
He publicado nuevos apuntes de 3º Microbiología Industrial: apuntestema9.docx
He publicado nuevos apuntes de 3º Microbiología Industrial: apuntestema82.docx
apuntes del parcial dos (desde tema 8_2 hasta 14). también hay preguntas de años anteriores contestadas y preguntas que ha dicho que podían salir en el examen en la clase
He publicado nuevos examenes de 3º Microbiología Industrial: Posibles-preguntas-examen-T8.1.pdf
He publicado nuevos examenes de 3º Microbiología Industrial: Posibles-preguntas-examen-T7.pdf
He publicado nuevos examenes de 3º Microbiología Industrial: Posibles-preguntas-examen-T6.pdf
He publicado nuevos examenes de 3º Microbiología Industrial: Posibles-preguntas-examen-T5.pdf
He publicado nuevos examenes de 3º Microbiología Industrial: Posibles-preguntas-examen-T4.pdf
He publicado nuevos examenes de 3º Microbiología Industrial: Preguntas-tipo-test-parcial-1-COMPLETO.pdf
He publicado nuevos examenes de 3º Microbiología Industrial: Posibles-preguntas-examen-T3.pdf
He publicado nuevos examenes de 3º Microbiología Industrial: Posibles-preguntas-examen-T2.pdf
He publicado nuevos examenes de 3º Microbiología Industrial: Posibles-preguntas-examen-T1.pdf
He publicado nuevos examenes de 3º Microbiología Industrial: Esquema-primer-parcial-examen-Microbiologia-Industrial-2024.pdf
He publicado nuevos examenes de 3º Microbiología Industrial: Esquema-examen-segundo-parcial-Microbiologia-industrial-2024.pdf
apuntes
-
Apuntes Teoria Parcial 1 MicroIndus
He publicado nuevos apuntes de 3º Microbiología Industrial: Apuntes Teoria Parcial 1 MicroIndus
He publicado nuevos examenes de 3º Microbiología Industrial: Examen-segundo-parcial 2025.pdf
test
-
CuestionesExamenesP2
He publicado nuevos test de 3º Microbiología Industrial: CuestionesExamenesP2
apuntes
-
Teoria_Parcial_2_MicroIndus
He publicado nuevos apuntes de 3º Microbiología Industrial: Teoria_Parcial_2_MicroIndus
He publicado nuevos apuntes de 3º Microbiología Industrial: Tema15-ActinomicetosyAntibioticos.pdf
He publicado nuevos apuntes de 3º Microbiología Industrial: Tabla-Biopolimeros-bacterianos.pdf
He publicado nuevos apuntes de 3º Microbiología Industrial: Tabla-antibioticos-principales-segun-profesora.pdf
He publicado nuevos apuntes de 3º Microbiología Industrial: Apuntes-2o-Parcial.pdf
apuntes
-
Apuntes segundo parcial
He publicado nuevos apuntes de 3º Microbiología Industrial: Apuntes segundo parcial
He publicado nuevos apuntes de 3º Microbiología Industrial: Examen-practicas-2025.pdf
He publicado nuevos practicas de 3º Microbiología Industrial: EX-PRACTICAS-MICRO-IND.pdf
Se supone que ya está (si al wuolah de mierda le da la gana actualizarse)
apuntes
-
Apuntes primer parcial
He publicado nuevos apuntes de 3º Microbiología Industrial: Apuntes primer parcial
apuntes
-
Preguntas tipo examen P1
Respuestas al final del documento :)
apuntes
-
Teoría Parcial 1
He publicado nuevos apuntes de 3º Microbiología Industrial: Teoría Parcial 1
He publicado nuevos apuntes de 3º Microbiología Industrial: Apuntes-micro-industrial.pdf
He publicado nuevos apuntes de 3º Microbiología Industrial: TEMARIO-COMPLETO-MI.pdf
He publicado nuevos practicas de 3º Microbiología Industrial: Preguntastestpracticasmicroindustrial.pdf
He publicado nuevos examenes de 3º Microbiología Industrial: test-practicas-poliformat.pdf
He publicado nuevos apuntes de 3º Microbiología Industrial: Parcial-1-Microbiologia-industrial.pdf
He publicado nuevos apuntes de 3º Microbiología Industrial: Apuntes-P1-Microbiologia-Industrial.pdf
He publicado nuevos trabajos de 3º Microbiología Industrial: Debate-bioprospeccion.pdf
He publicado nuevos trabajos de 3º Microbiología Industrial: BIOPROSPECCION.pdf
He publicado nuevos apuntes de 3º Microbiología Industrial: Teoria-MI-paula.pdf
He publicado nuevos examenes de 3º Microbiología Industrial: Examen-Micro.pdf
He publicado nuevos examenes de 3º Microbiología Industrial: Preguntas-2o-parcial-micro.pdf
He publicado nuevos examenes de 3º Microbiología Industrial: Compendio-Preguntas-1o-Parcial.pdf
He publicado nuevos examenes de 3º Microbiología Industrial: Preguntas-primer-parcial.pdf
He publicado nuevos examenes de 3º Microbiología Industrial: 2-Parcial-Micro.pdf
He publicado nuevos apuntes de 3º Microbiología Industrial: Microbiologia-industrial-temario-completo.pdf
He publicado nuevos apuntes de 3º Microbiología Industrial: MI-preguntas-parcial-2.pdf